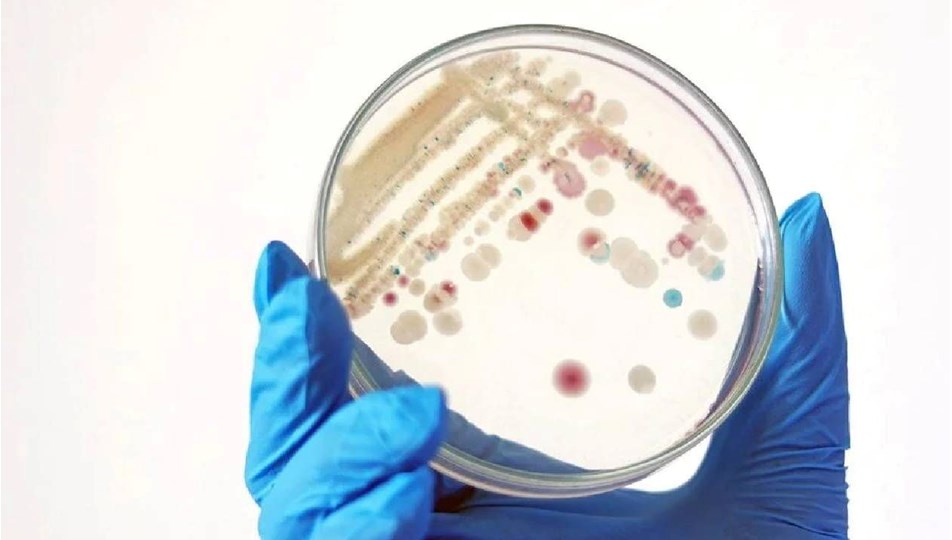

ABD’de “et yiyen bakteri” alarmı: 2025’te 9 kişi öldü

ABD’de “et yiyen” bakteri olarak bilinen Vibrio vulnificus vakalarda önemli bir artış yaşanıyor.
Louisiana ve Florida’da enfekte olan en az dokuz kişi hayatını kaybetti.
The Washington Times’ın haberine göre Florida’da 2025’te 16 Vibrio vulnificus vakası görüldü ve bu hastalardan beşi hayatını kaybetti.
Louisiana’da ise 30 Temmuz itibarıyla 17 kişi enfeksiyona yakalandı, bunlardan dördü öldü.
Teksas Sağlık Hizmetleri Departmanı, bu yıl eyalette beş Vibrio vulnificus vakası bildirildiğini, ancak ölüm olmadığını duyurdu.
Mississippi Sağlık Bakanlığı, 2025’te eyalette 13 vaka görüldüğünü, ölüm yaşanmadığını bildirdi.
YÜZDE 20’Sİ ÖLÜYOR
ABD Hastalık Kontrol ve Önleme Merkezleri’ne (CDC), göre her yıl 150 ila 200 arası Vibrio vulnificus vakası bildiriliyor ve bu hastaların %20’si hayatını kaybediyor. Ancak bu yıl vaka sayısında belirgin bir artış var.
AÇIK YARADAN VÜCUDA GİRİYOR
Bu bakteri genellikle ılık ve hafif tuzlu deniz suyunda yaşıyor ve açık yaralarından vücuda girebiliyor.
Çiğ kabuklu deniz ürünleri, özellikle de çiğ istiridye tüketiminin de enfeksiyon kaynağı olabileceği belirtiliyor.
BELİRTİLERİ NELER?
Vibrio vulnificus genellikle kusma, ishal ve karın ağrısıyla seyreden vibriozis adı verilen bir hastalığa yol açabiliyor.
Bakterinin kana karışması durumunda ateş, titreme, septik şok ve kabarcıklı deri lezyonları ile seyreden ağır bir hastalığa neden olabiliyor.
Bazı ciddi vakalarda bakteri, yaralı dokunun ölmesine neden olan nekrotizan fasiit adı verilen bir enfeksiyona yol açabiliyor.
Bu nadir komplikasyon, bakterinin halk arasında “et yiyen bakteri” olarak anılmasına yol açıyor.
ABD’de “et yiyen bakteri” alarmı: 2025’te 9 kişi öldüABD’nin güney eyaletlerinde et yiyen bakteri paniği yaşanıyor. Onlarca vaka rapor edildi, Louisiana ve Florida’da 9 kişi öldü.
08.08.2025 – 07:05
ntv.com.tr
ABD’de “et yiyen” bakteri olarak bilinen Vibrio vulnificus vakalarda önemli bir artış yaşanıyor.
Louisiana ve Florida’da enfekte olan en az dokuz kişi hayatını kaybetti.
The Washington Times’ın haberine göre Florida’da 2025’te 16 Vibrio vulnificus vakası görüldü ve bu hastalardan beşi hayatını kaybetti.
Louisiana’da ise 30 Temmuz itibarıyla 17 kişi enfeksiyona yakalandı, bunlardan dördü öldü.
Teksas Sağlık Hizmetleri Departmanı, bu yıl eyalette beş Vibrio vulnificus vakası bildirildiğini, ancak ölüm olmadığını duyurdu.
Mississippi Sağlık Bakanlığı, 2025’te eyalette 13 vaka görüldüğünü, ölüm yaşanmadığını bildirdi.
YÜZDE 20’Sİ ÖLÜYOR
ABD Hastalık Kontrol ve Önleme Merkezleri’ne (CDC), göre her yıl 150 ila 200 arası Vibrio vulnificus vakası bildiriliyor ve bu hastaların %20’si hayatını kaybediyor. Ancak bu yıl vaka sayısında belirgin bir artış var.
AÇIK YARADAN VÜCUDA GİRİYOR
Bu bakteri genellikle ılık ve hafif tuzlu deniz suyunda yaşıyor ve açık yaralarından vücuda girebiliyor.
Çiğ kabuklu deniz ürünleri, özellikle de çiğ istiridye tüketiminin de enfeksiyon kaynağı olabileceği belirtiliyor.
BELİRTİLERİ NELER?
Vibrio vulnificus genellikle kusma, ishal ve karın ağrısıyla seyreden vibriozis adı verilen bir hastalığa yol açabiliyor.
Bakterinin kana karışması durumunda ateş, titreme, septik şok ve kabarcıklı deri lezyonları ile seyreden ağır bir hastalığa neden olabiliyor.
Bazı ciddi vakalarda bakteri, yaralı dokunun ölmesine neden olan nekrotizan fasiit adı verilen bir enfeksiyona yol açabiliyor.
Bu nadir komplikasyon, bakterinin halk arasında “et yiyen bakteri” olarak anılmasına yol açıyor.
- Etiketler :
- Haberler –
- Hastalık
- Abd
- Bakteri
Haber Kaynak : NTV.COM.TR
“Yayınlanan tüm haber ve diğer içerikler ile ilgili olarak yasal bildirimlerinizi bize iletişim sayfası üzerinden iletiniz. En kısa süre içerisinde bildirimlerinize geri dönüş sağlanılacaktır.”